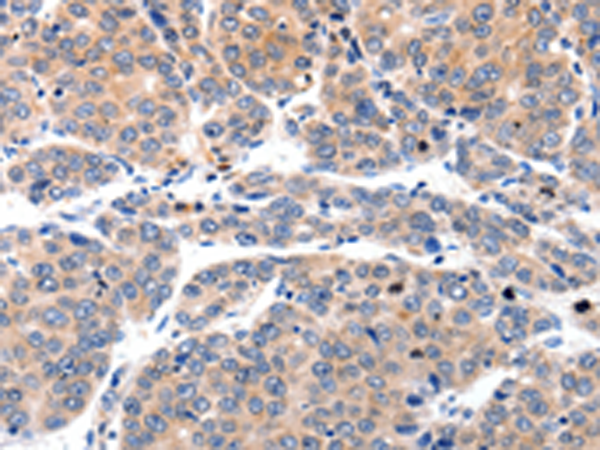

中文名稱: 兔抗MYL9多克隆抗體
英文名稱: Anti-MYL9 rabbit polyclonal antibody
別 名: LC20, MLC2, MRLC1, MYRL2, MLC-2C
相關(guān)類別: 一抗
儲 存: 冷凍(-20℃)
宿 主: Rabbit
抗 原: MYL9
反應(yīng)種屬: Human, Mouse, Rat
標(biāo) 記 物: Unconjugate
克隆類型: rabbit polyclonal
技術(shù)規(guī)格
|
Background: |
Myosin, a structural component of muscle, consists of two heavy chains and four light chains. The protein encoded by this gene is a myosin light chain that may regulate muscle contraction by modulating the ATPase activity of myosin heads. The encoded protein binds calcium and is activated by myosin light chain kinase. Two transcript variants encoding different isoforms have been found for this gene. |
|
Applications: |
ELISA, WB, IHC |
|
Name of antibody: |
MYL9 |
|
Immunogen: |
Synthetic peptide of human MYL9 |
|
Full name: |
myosin, light chain 9, regulatory |
|
Synonyms: |
LC20, MLC2, MRLC1, MYRL2, MLC-2C |
|
SwissProt: |
P24844 |
|
ELISA Recommended dilution: |
2000-10000 |
|
IHC positive control: |
Human liver cancer and Human cervical cancer |
|
IHC Recommend dilution: |
50-200 |
|
WB Predicted band size: |
14 kDa |
|
WB Positive control: |
Jurkat and 231 cells |
|
WB Recommended dilution: |
1000-5000 |

購物車
幫助
021-54845833/15800441009
